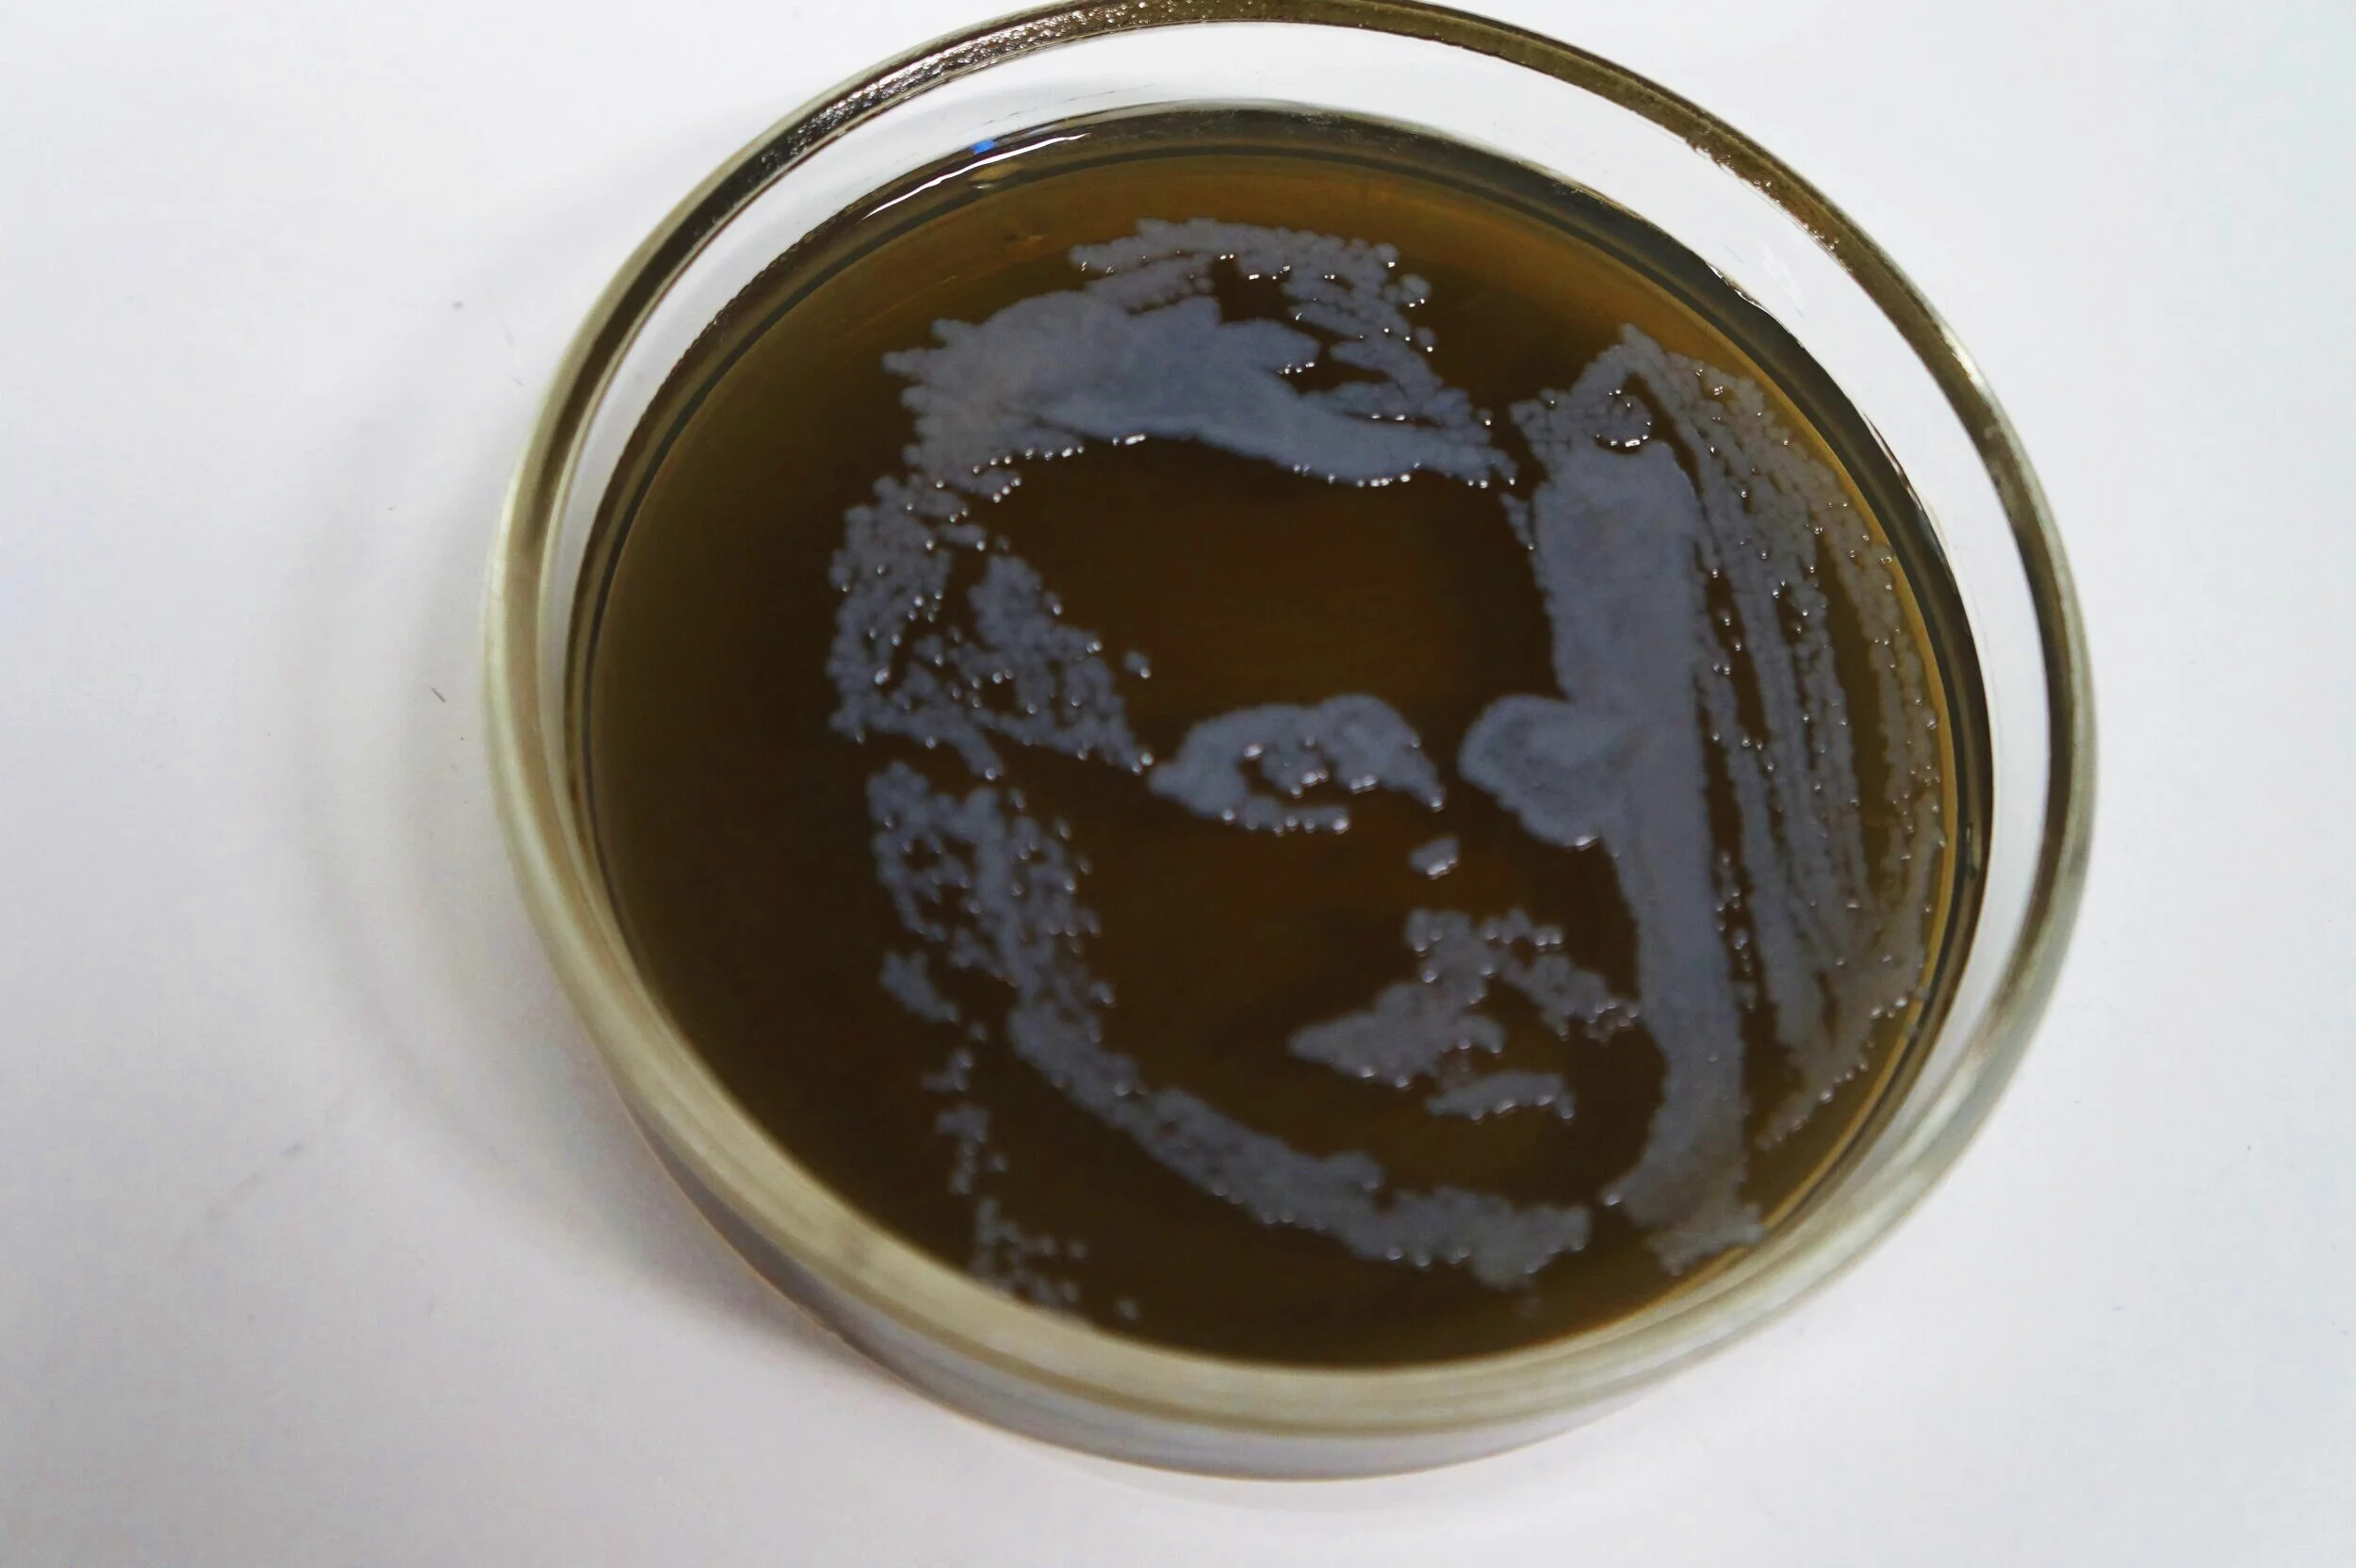
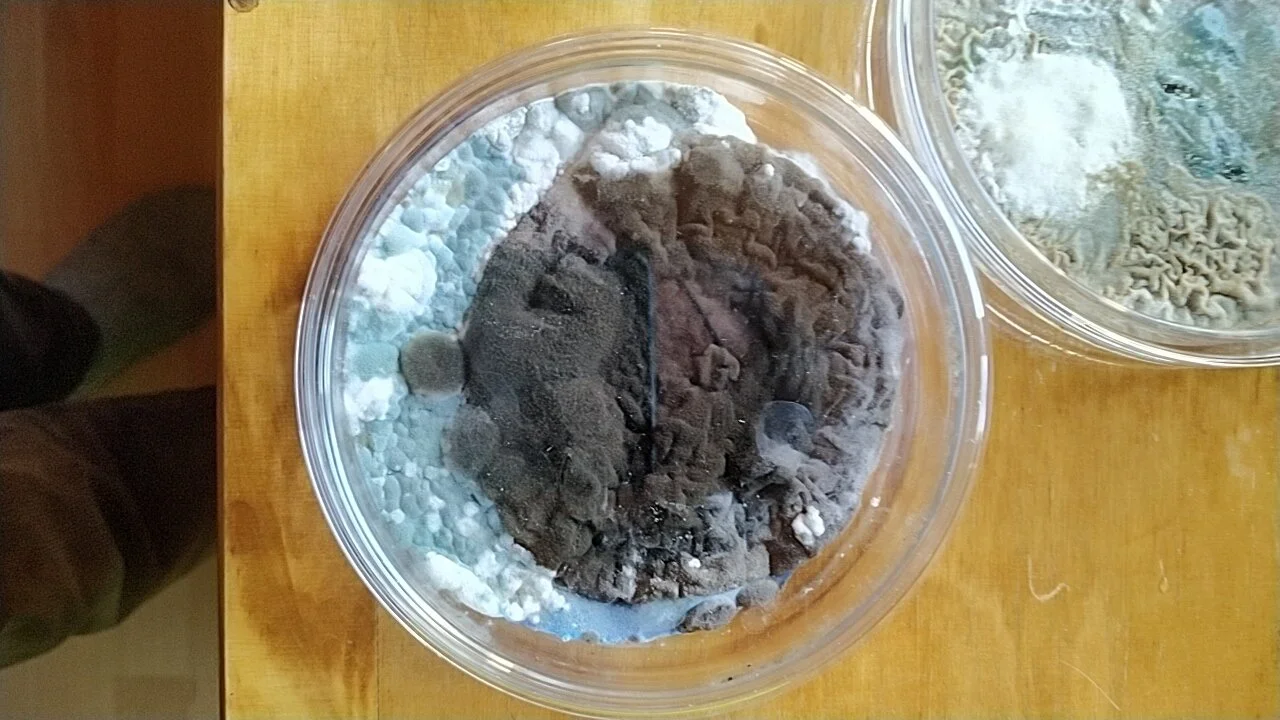

Yeastotract: young Jean Sibelius’ portrait
Pichia pastoris
on Black YPD medium







Aspergillus spp.
on Blue YPD medium